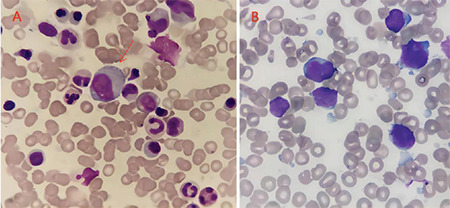

一例费城染色体阳性急性淋巴细胞白血病并存 JAK2 V617F 克隆的病例
IF 1.3
4区 医学
Q3 HEMATOLOGY
Turkish Journal of Hematology
Pub Date : 2024-05-30
Epub Date: 2024-03-26
DOI:10.4274/tjh.galenos.2024.2023.0467
引用次数: 0
摘要
本文章由计算机程序翻译,如有差异,请以英文原文为准。

A Case of Philadelphia Chromosome-Positive Acute Lymphoblastic Leukemia with Coexistence of the JAK2V617F Clone
求助全文
通过发布文献求助,成功后即可免费获取论文全文。
去求助
来源期刊

Turkish Journal of Hematology
HEMATOLOGY-
CiteScore
2.90
自引率
3.80%
发文量
45
审稿时长
1 months
期刊介绍:
The Turkish Journal of Hematology is published quarterly (March, June, September, and December) by the Turkish Society of Hematology. It is an independent, non-profit peer-reviewed international English-language periodical encompassing subjects relevant to hematology.
The Editorial Board of The Turkish Journal of Hematology adheres to the principles of the World Association of Medical Editors (WAME), International Council of Medical Journal Editors (ICMJE), Committee on Publication Ethics (COPE), Consolidated Standards of Reporting Trials (CONSORT) and Strengthening the Reporting of Observational Studies in Epidemiology (STROBE).
The aim of The Turkish Journal of Hematology is to publish original hematological research of the highest scientific quality and clinical relevance. Additionally, educational material, reviews on basic developments, editorial short notes, images in hematology, and letters from hematology specialists and clinicians covering their experience and comments on hematology and related medical fields as well as social subjects are published. As of December 2015, The Turkish Journal of Hematology does not accept case reports. Important new findings or data about interesting hematological cases may be submitted as a brief report.
 求助内容:
求助内容: 应助结果提醒方式:
应助结果提醒方式:


